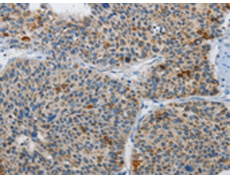
一抗

中文名稱:兔抗ATG4A多克隆抗體
|
Background: |
Autophagy is the process by which endogenous proteins and damaged organelles are destroyed intracellularly. Autophagy is postulated to be essential for cell homeostasis and cell remodeling during differentiation, metamorphosis, non-apoptotic cell death, and aging. Reduced levels of autophagy have been described in some malignant tumors, and a role for autophagy in controlling the unregulated cell growth linked to cancer has been proposed. This gene encodes a member of the autophagin protein family. The encoded protein is also designated as a member of the C-54 family of cysteine proteases. Transcript variants that encode distinct isoforms have been identified. |
|
Applications: |
ELISA, WB, IHC |
|
Name of antibody: |
ATG4A |
|
Immunogen: |
Synthetic peptide of human ATG4A |
|
Full name: |
autophagy related 4A, cysteine peptidase |
|
Synonyms: |
APG4A; AUTL2 |
|
SwissProt: |
Q8WYN0 |
|
ELISA Recommended dilution: |
2000-5000 |
|
IHC positive control: |
Human liver cancer and Human brain |
|
IHC Recommend dilution: |
25-100 |
|
WB Predicted band size: |
45 kDa |
|
WB Positive control: |
231 cells and human liver cancer tissue |
|
WB Recommended dilution: |
200-1000 |


 購(gòu)物車
購(gòu)物車 幫助
幫助
 021-54845833/15800441009
021-54845833/15800441009